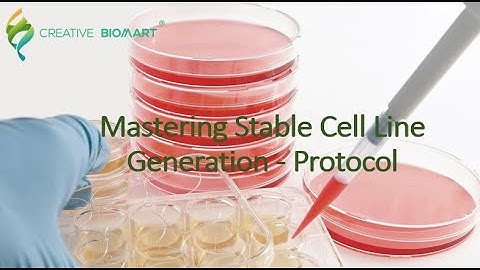
Mastering Stable Cell Line Generation - Protocol

⬇ DOWNLOAD NOW
Kalau muncul iklan pop-up, tutup lalu klik tombol kembali
Download lagu VectorBuilder | Generation of Stable Cell Lines secara gratis hanya untuk keperluan promosi. Dukung artis favorit kamu dengan membeli musik original di iTunes atau platform resmi lainnya.
 Stage 1 of 3: Generation of Stable, Transfected Cell Lines: Kill Curve
Stage 1 of 3: Generation of Stable, Transfected Cell Lines: Kill Curve
 Stage 3 of 3: Generation of Stable, Transfected Cell Lines: Selection
Stage 3 of 3: Generation of Stable, Transfected Cell Lines: Selection
 Protocol for Generation of Stable Cell Lines
Protocol for Generation of Stable Cell Lines
 Generation: Stable Human Cell Lines With Tet-on shRNA/cDNA Expression l Protocol Preview
Generation: Stable Human Cell Lines With Tet-on shRNA/cDNA Expression l Protocol Preview
 An introduction to cell-line development
An introduction to cell-line development
 Stage 2 of 3: Generation of Stable, Transfected Cell lines: Transfection
Stage 2 of 3: Generation of Stable, Transfected Cell lines: Transfection
Mastering Stable Cell Line Generation - Protocol
Mastering Stable Cell Line Generation - Protocol
 Webinar: TARGATT™ Master Cell Lines for Stable Cell Line Generation and Mammalian Library Screens
Webinar: TARGATT™ Master Cell Lines for Stable Cell Line Generation and Mammalian Library Screens